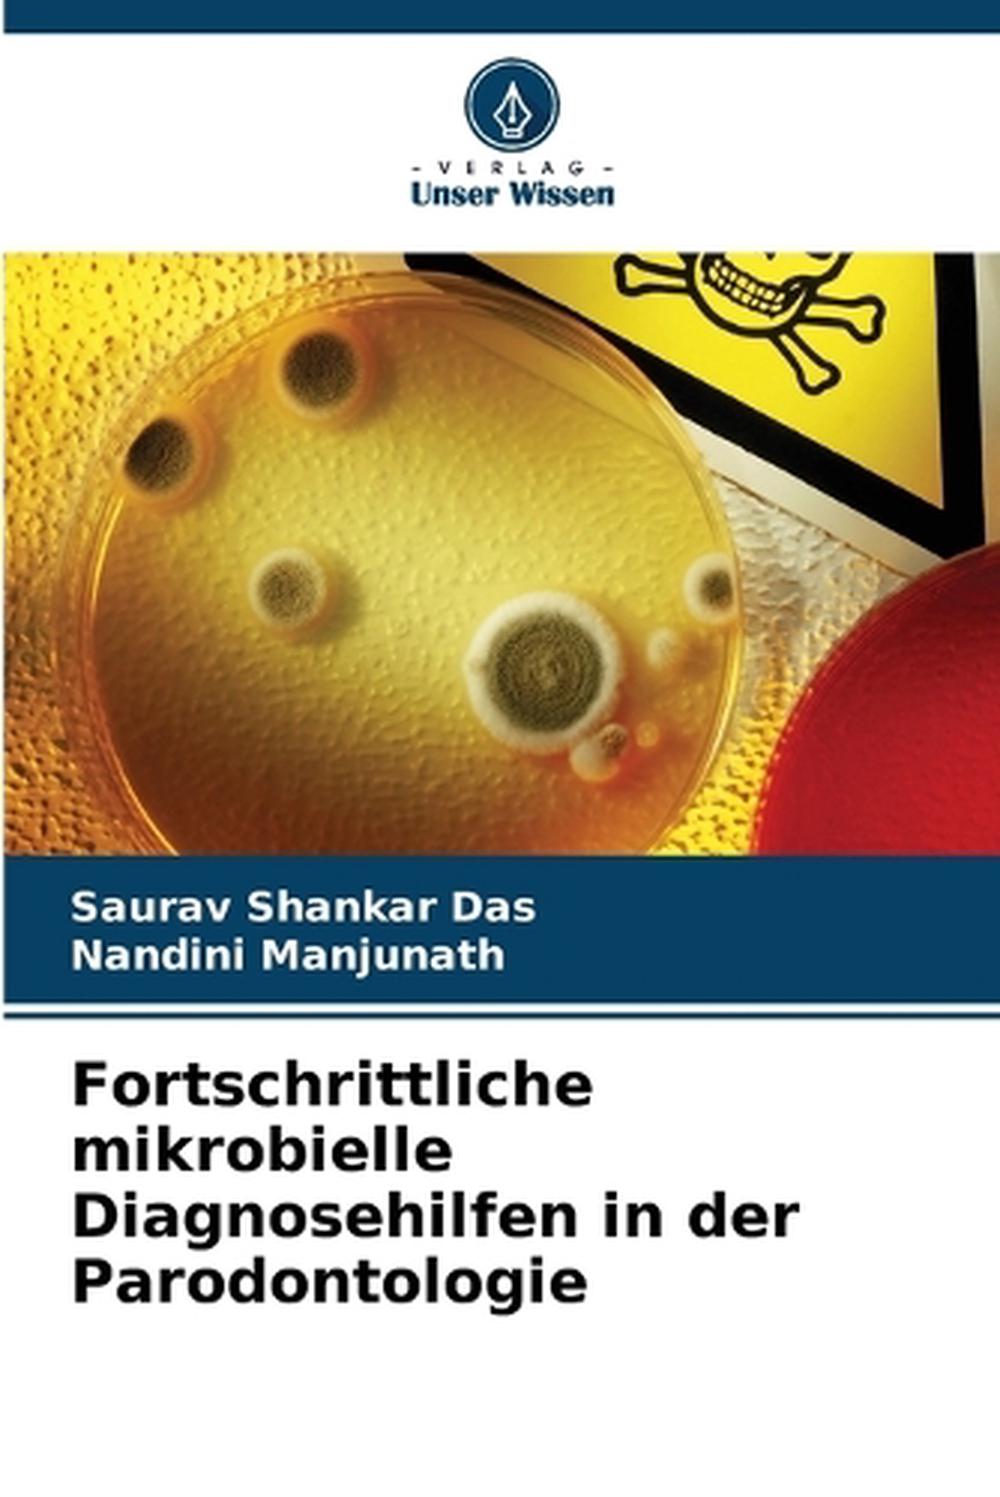

Fortschrittliche mikrobielle Diagnosehilfen in der Parodontologie
by Saurav Shankar Das, Nandini ManjunathEstimated delivery 3-12 business days
Format Paperback
Condition Brand New
Description Das vorliegende Buch soll die Fähigkeit mehrerer Nachweismethoden vergleichen, d. h. einer anaeroben Kultur mit serieller Verdünnung und/oder eines mikroskopischen Verfahrens, eines DNA-Sondenverfahrens und immunologischer Reagenzien unter Verwendung sowohl eines Enzymimmunoassays (ELISA) als auch eines indirekten Immunfluoreszenzassays (IFA), um eine ausgewählte Gruppe parodontopathischer Organismen in einzelnen subgingivalen Plaqueproben aus parodontal erkrankten Stellen nachzuweisen.